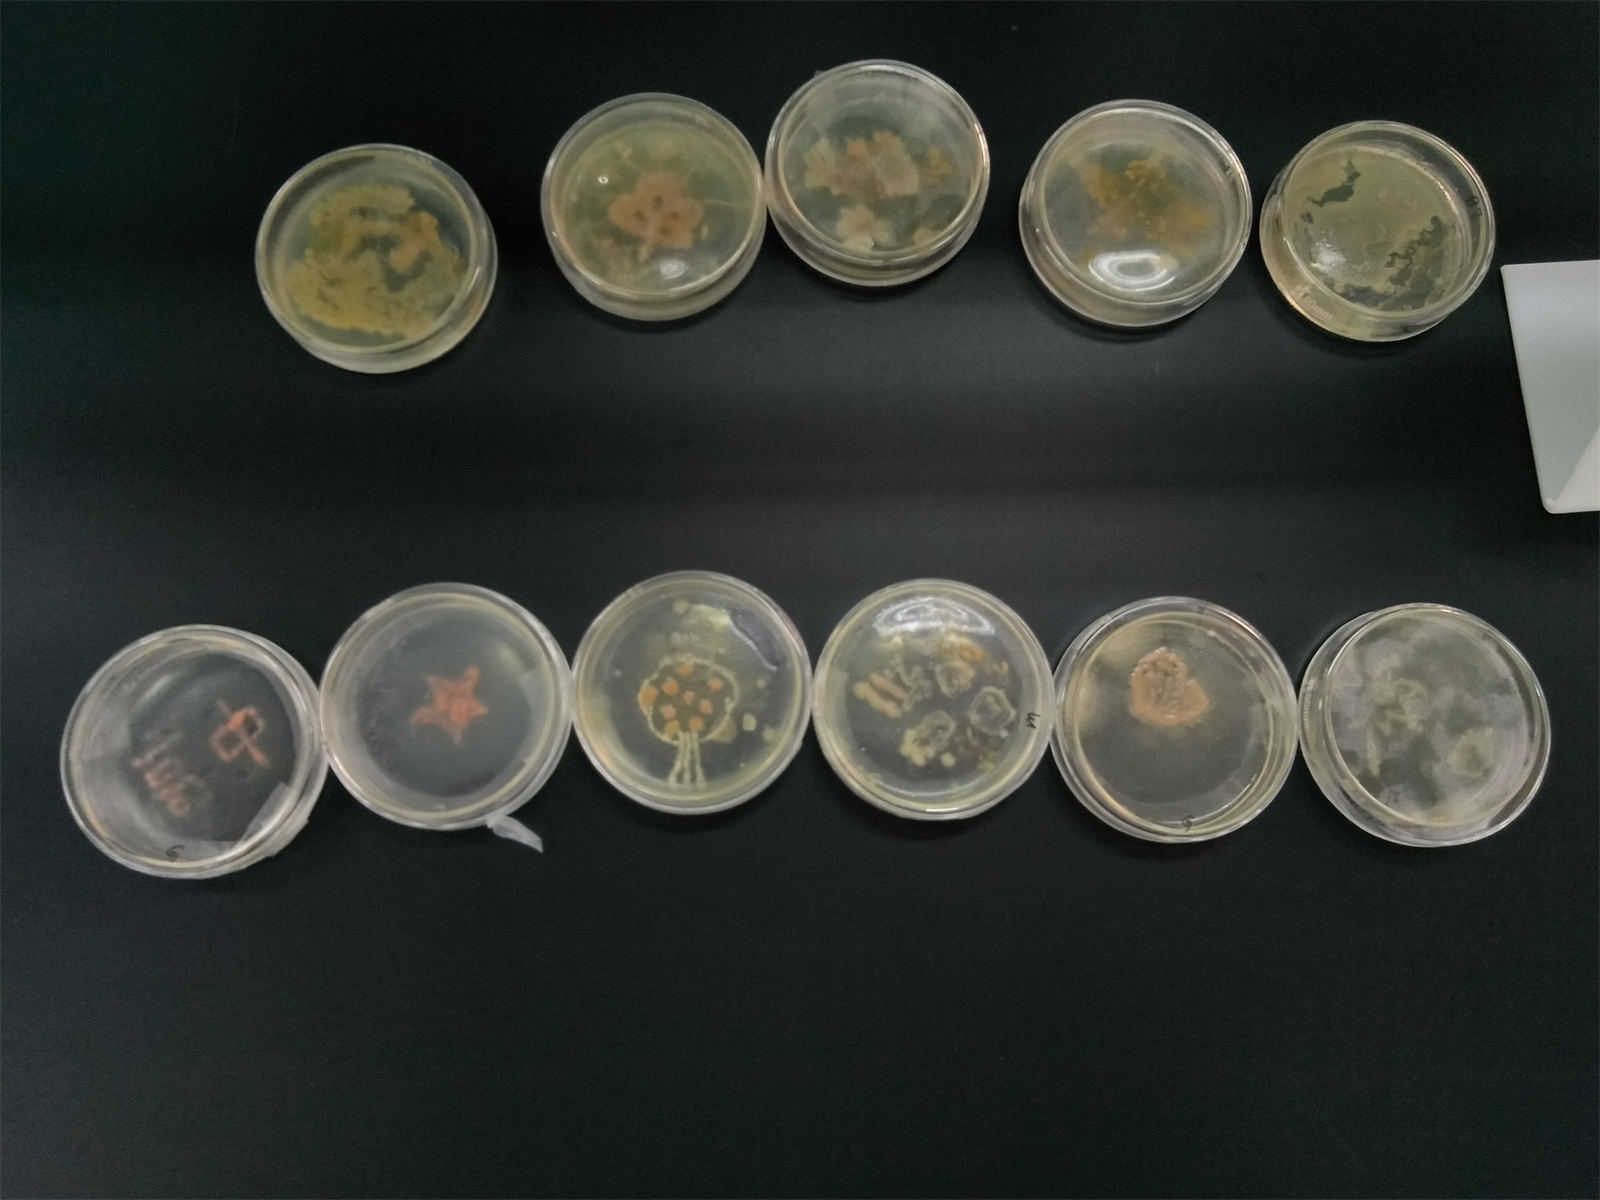

2022年4月28日上午,莆田市高二生物学科教学研讨活动在莆田五中举行。本次活动主题为“高中生物实验教学实践研讨”,全市高中各校高二生物备课组组长、市高二生物学科中心组成员、各县区生物教研员等参加。活动由市教师进修学院生物教研员蔡群峰老师主持。
参会老师们首先观摩了莆田第五中学陈清霞老师主题为《植物组织培养——分析、交流与评价》的公开课。课前,学生们在清霞老师指导下认真研读教材、查阅论文、开展实践,取得很好的实验成果和实践体验。课上,各实验小组积极分享实验成果和体会,也提出了染菌现象、培养基配制等问题和困惑,并进一步地通过组内合作和组间互助分析、解决相关问题。此外,清霞老师还组织学生开展进一步探究,使实验活动得到很好的延伸。




听课老师对本节课给予了充分的肯定,认为本节课注重培养学生的核心素养,学生在动手实验中获得深刻的实践体验;教师通过组织小组分享、问题讨论、探究方案设计等活动安排,关注学生学习能力提升,体现学生课堂主体作用,促进课堂效率的提升。同时,关于如何更加有效解决实验操作出现的问题,落实生物实验的高效课堂提出一些建议。


莆田五中生物教研组组长林荔进行《莆田市第五中学生物综合创新实验室的建设和使用》专题讲座。林荔老师分享了莆田五中生物创新实验室的建设和使用经验,介绍教研组老师经过长期的努力探索在植物组织培养、无土栽培、微生物培养、传感器使用等实验教学上取得的一系列成果,同时也谈到其中的艰辛和困难。蔡群峰教研员在总结中指出生物学学科核心素养的培养注重学生实践和体验,五中生物老师通过积极研究和探索在生物创新实验教学上取得了丰富成果,积累了不少经验,值得各校学习和借鉴。





参会老师们还参观了生物创新实验室,观看组培苗、拇指植物、无土栽培植物、细菌作画等成果展示,品尝用实验室培养出来的铁皮石斛和金线莲泡制的茶,并与五中生物老师们进行深入交流。大家表示今天的研讨活动收获满满,对生物实验教学的深化与提升也有更多的思考。

撰稿:马学乔